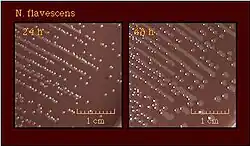
Ilustracja

Neisseria flavescens
![]() Kolonie N. flavescens w 24 i 48 godzinie hodowli | |
| Systematyka | |
| Domena | |
|---|---|
| Typ | |
| Klasa |
betaproteobakterie |
| Rząd | |
| Rodzina | |
| Rodzaj | |
| Gatunek |
Neisseria flavescens |
| Nazwa systematyczna | |
| Neisseria flavescens Branham 1930 | |
Neisseria flavescens – gatunek Gram-ujemnej bakterii opisany po raz pierwszy podczas epidemii zapalenia opon mózgowo-rdzeniowych w Chicago w 1928 roku[1]. Bakteria ta nie fermentuje węglowodanów ani nie redukuje azotanów, wytwarza natomiast katalazę[2][3]. Jej pozycja taksonomiczna nie jest pewna – z jednej strony tak jak niektóre komensalne gatunki Neisseria, jest wrażliwa na kolistynę oraz wytwarza polisacharydy z sacharozy, z drugiej strony badania wykorzystujące hybrydyzację kwasów nukleinowych dowiodły, że jest blisko spokrewniona z chorobotwórczymi gatunkami Neisseria – co sugeruje, że N. flavescens może być organizmem hybrydowym[2]. Ponadto, Bennet et al., (2012) zasugerowali, że gatunek ten może być w rzeczywistości biotypem Neisseria subflava[4]. N. flavescens zasiedla ludzką jamę ustną, wykrywana była również w tkankach innych zwierząt takich jak psy, uszanka kalifornijska, przepiór wirginijski czy stonoga murowa[5]. Gatunek ten sporadycznie wywołuje stany patologiczne takie jak posocznica, zapalenie wsierdzia, czy zapalenie opon mózgowo-rdzeniowych[3].
Przypisy
- ↑ Sara E. Branham, A New Meningococcus-like Organism (Neisseria flavescens n. sp.) from Epidemic Meningitis, „Public Health Reports (1896-1970)”, 45 (16), 1930, s. 845–849, DOI: 10.2307/4579618, ISSN 0094-6214, JSTOR: 4579618 [dostęp 2020-06-15].
- 1 2 Neisseria flavescens - Gonorrhea - STD Information from CDC [online], www.cdc.gov, 11 stycznia 2019 [dostęp 2020-06-15] (ang.).
- 1 2 NCI Thesaurus [online], ncithesaurus.nci.nih.gov [dostęp 2020-06-15].
- ↑ Julia S. Bennett i inni, A genomic approach to bacterial taxonomy: an examination and proposed reclassification of species within the genus Neisseria, „Microbiology”, 158 (Pt 6), 2012, s. 1570–1580, DOI: 10.1099/mic.0.056077-0, ISSN 1350-0872, PMID: 22422752, PMCID: PMC3541776 [dostęp 2020-06-15].
- ↑ Guangyu Liu, Christoph M. Tang, Rachel M. Exley, Non-pathogenic Neisseria: members of an abundant, multi-habitat, diverse genus, „Microbiology”, 161 (7), 2015, DOI: 10.1099/mic.0.000086;jsessionid=5cg-ohqyugogv03aw3ijja4y.mbslive-10-240-10-88#mic000086-branham1, ISSN 1350-0872 [dostęp 2020-06-15] (ang.).